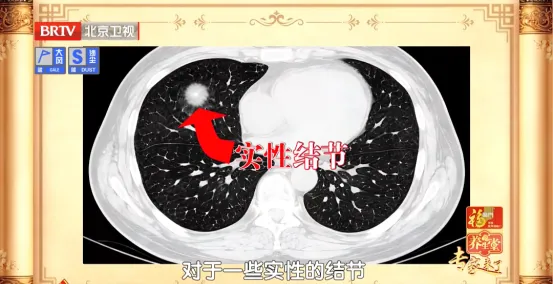
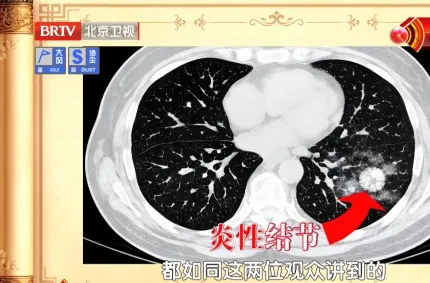

现在体检,十个人里有七八个会查出肺结节,很多人一看到报告单就忧心忡忡:会不会发展成癌?要不要手术?

现在体检,十个人里有七八个会查出肺结节,很多人一看到报告单就忧心忡忡:会不会发展成癌?要不要手术?
其实大多数肺结节并不可怕,在中医眼里,它就是肺里没排干净的“小疙瘩”——有的是炎症留下的,有的是肺气弱、痰排不出去堵出来的。

分清类型、调补肺气、把痰化掉,很多结节能稳住、变小,不用天天提心吊胆!
01
你的结节是炎性结节吗?
试试这两个茶饮方
1
专家教你看结节报告
医生拿到CT报告,不光要看结节大小,更看重它的“长相”。
磨玻璃结节和混合性结节,这两种是更被重视的;

反过来,如果是边缘清清楚楚的实性结节,那多半是个“老疤痕”,也就是陈旧性结节,不用太紧张。
一般我们从报告上也可以看出来,只要留意一下医生写的内容:
如果报告上写“请专科会诊”等类似话术,那说明这个结节需要找专家再仔细看看,多半是磨玻璃或者混合性的。
如果报告上写“考虑炎性可能更大”,那就是告诉您,这很可能是炎症引起的炎性肺结节。
炎性结节有个特点:往往个头不小,有的能到一两厘米,里面比较实,但没有癌症那种“凶相”。

医生看了之后,如果没让马上手术或者进一步检查,那八成就是炎性的。这种结节不用担心,用抗炎药或者中药调理,慢慢就能缩小。
2
两个茶饮方“化掉”炎性结节
中医认为,炎性结节往往是痰和热堵在肺里形成的。针对不同体质,专家给出了两个简单的茶饮方。
护肺茶饮方1:适合偏热体质
【组方】
紫苏叶1-2g、玫瑰花3-5朵、夏枯草1-2棵

【禁忌】
脾胃虚弱的人不建议喝。
【方解】
①紫苏叶轻灵,解油腻、能化痰,能够散发肺中瘀浊,泡水后清香味十足。
②夏枯草是化痰“猛将”,具有极强的寒性,能清理体内的热痰,适合体质偏热/偏燥、痰火比较重的(咳黄痰)、平时特别怕热的人。

③结节产生意味着必有瘀滞,玫瑰花可以疏肝理气、活血化瘀,特别适合女性。
总体来说,苏叶清上焦之热/痰,有散的力量,夏枯草有向下清的力量,两者配合起来,一升一降、一散一清,可化痰。再加上玫瑰花把道路打通,让邪有出路。
护肺茶饮方2:适合脾胃虚弱的人
大便不成形、吃了凉食不舒服的人,尽量避免使用夏枯草,推荐用陈皮。下面这杯茶,就更适合脾胃虚弱的炎性肺结节患者。
【组方】
陈皮3-4克,蒲公英1-2克。

【方解】
中医认为,脾为生痰之源、肺为贮痰之器。脾胃寒、脾胃弱,则不能化掉身体里的很多物质,生成了垃圾存在肺里。
陈皮单用效力比较低,适合年轻人;年龄大一些的,因为人的正气随着年龄下降,这时候用组合药比用单药好。
陈皮泡水有点温,有胃火的人(比如反酸),就可以搭配蒲公英。

02
肺气不足,容易长结节!
两个动作自测
在中医看来,得肺结节的人,绝大多数都存在肺气不足的情况。尤其是炎性结节,跟肺气不足的关系非常密切。
1
肺气不足为什么易长结节
肺为水之上源,它喜欢湿润、怕干燥,有通调水道的作用。如果肺气够强,它就能把身体里的痰啊、垃圾啊顺着水路排出去。

另外,如果身体某个地方老是发炎、反反复复好不了,时间长了就容易长出小疙瘩——长在肺上,就是肺结节。
2
两招自测肺气足不足
专家带来两个小测试,既简单又实用。

◎打哈欠深浅:深吸气打哈欠,如果能打得又深又长,说明肺气不错;如果哈欠短浅、打不透,可能肺气不足。

◎握拳呼吸测试:把大拇指握在四指里面(相当于攥住了肺经),然后使劲握拳,同时正常说话。如果说话明显气喘、憋得慌,说明肺气偏弱。

3
肺气不足的典型表现
专家总结了肺气不足的典型表现,同时提醒我们,如果肺气不足比较轻,可以通过生活方式调整、运动锻炼来改善肺功能;
如果程度比较重,需要坚持使用中药茶饮以及中药治疗来解决问题。
符合3个表现,就是肺气不足了:乏力、气短/少气、嗓子干哑、容易打喷嚏、皮肤过敏瘙痒、稍受刺激就容易气喘/咳嗽。

4
五元养肺饮,把肺气补回来
专家带来了她调理肺结节的私房方,特别适合中年以上肺气不足、需要说很多话的人来喝。
【组方】
生黄芪10克、百合10克、桔梗6克、薄荷6克、化橘红6克。煮水喝,对于血糖正常的人,可以加冰糖/蜂蜜调节苦味。

【禁忌】
这杯茶不适合痰火太盛的人。
【方解】
肺容易肺气不足、肺阴不足,容易被痰黏住,所以在配伍时,首先讲究补肺气、养肺阴,这时候可以选择生黄芪。
生的黄芪有生发之气,走肺胃之表。中医认为,肺主皮毛,皮毛即卫气,卫气是保护我们身体的。也就是说,黄芪可以增强卫气功能、增强防御能力。
同时,补气容易上火,而百合润肺,因此,黄芪与百合搭配,一阴一阳、一动一静,非常适合。

桔梗化痰、利咽,薄荷疏风解表、利咽清肝,薄荷是一味非常好的把邪气带出去的药物。化橘红化痰之力强于陈皮,能让邪气往外走。

整体而言,该组方可以形成非常好的肺生态场。
03
肺脾两虚的人
容易得磨玻璃结节
1
肺脾两虚的表现
中医常说:脾为生痰之源,肺为贮痰之器。脾虚的人,容易肺气不足。

脾胃一虚,吃进去的东西化不掉,一直生痰湿;
肺气一虚,又没力气把痰排出去,越积越重;
痰湿堵在肺里排不净,时间一长,就容易形成磨玻璃结节。
肺脾两虚的典型表现:气短懒言、怕风易感冒、吃不下、拉不稠、浑身乏力、面色偏白、舌有齿痕。

2
肺脾双补十大食物排行榜
专家带来一张“肺脾双补十大食物排行榜”,快来看看有你喜欢吃的吗?
第1名:山药比芡实更均衡,肺脾肾三脏同补,平和且补益力强。

第2名:芡实肺脾肾都可以补,固精止泻,有托举的能力。

第3名:大枣不仅可以补气,还能补血。

第4名:白扁豆健脾渗湿,现代人湿气重,白扁豆很适合。

第5名:南瓜健脾,主打平和,基本什么人都能用。

第6名:银耳适合肺胃肠燥(尤其和百合、莲子搭配一起),不过现代人湿气重,要谨慎选择。
第7名:百合补肺阴、胃阴。
第8名:莲子健脾止泻,但莲子清火,略微偏寒,心火旺可以用,比较虚的话不适合。

第9名:蜂蜜是润肺好手,也可以润肠通便,但由于蜂蜜过润作腻,也能碍脾。

第10名:糯米。糯米是健脾养胃的好手,但由于有点滋腻碍胃,肠道排泄不畅的人不适合。

3
太白玉斛饮
许主任分享了一杯能够肺脾双补、养气养阴的代茶饮。
组成:太子参10克、炒白术10克、玉竹10克、石斛8克、陈皮3克

04
学会肺部锻炼操
帮您调理肺结节
想让肺气更足,运动特别管用,所有长肺结节的人都适合练。
专家今天教我们的这套肺部锻炼操,是从老祖宗的养生功法《易筋经》里来的,有助于强身健体、延年益寿。
点击视频,看专家演示
查出肺结节,先别慌、别焦虑。坚持练养肺操、喝养肺茶,把肺气补足,结节就能稳得住、慢慢小


